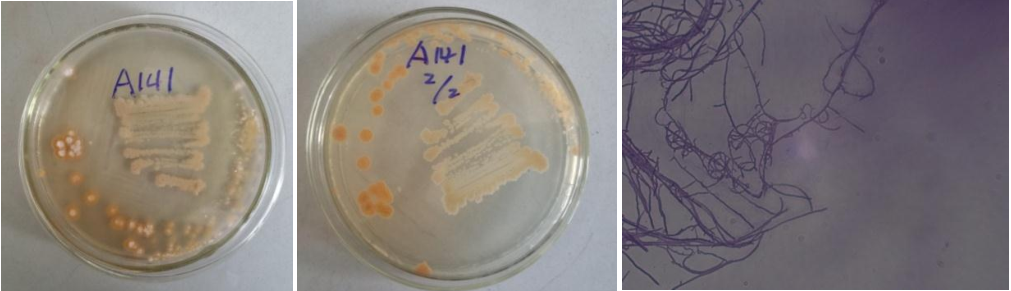

Loading...
| StrainNO | A141 |
| Classification | Streptomyces |
| 16s rDNA sequence | GACGAACGCTGGCGGCGTGCTTAACACATGCAAGTCGAACGGTGAAGCCTTTTGGGGTGGATCAGTGGCGAACGGGTGAGTAAC ACGTGGCAATCTGCCCTGCACTCTGGGATAAGCCTTGGAAACGGGGTCTAATACCGGATATGACATGGGAGCGCATGTTTCTGT GTGGAAAGTTTCGGCGGTGTAGGATGAGCTCGCGGCCTATCAGCTTGTTGGTGGGGTGATGGCCTACCAAGGCGACGACGGGTA GCCGGCCTGAGAGGGCGATCGGCCACACTGGGACTGAGACACGGCCCAGACTCCTACGGGAGGCAGCAGTGGGGAATATTGCAC AATGGGCGAAAGCCTGATGCAGCGACGCCGCGTGGGGGATGACGGCCTTCGGGTTGTAAACCTCTTTCAGCAGGGAAGAAGCCT TTGGGTGACGGTACTTGCAGAAGAAGCACCGGCTAACTACGTGCCAGCAGCCGCGGTAATACGTAGGGTGCGAGCGTTGTCCGG AATTATTGGGCGTAAAGAGCTCGTAGGCGGCTTGTTGCGTCGGATGTGAAAGCCCGGGGCTTAACCTCGGGTCTGCATTCGATA CGGGCAGGCTGGAGTTCGGTAGGGGAGATCGGAATTCCTGGTGTAGCGGTGAAATGCGCAGATATCAGGAGGAACACCGGTGGC GAAGGCGGATCTNTGNGCCGATACTGACGCTGAGGAGCGAAAGCGTGGGGAGCGAACAGGATTAGATACCCTGGTAGTCCACGC CGTAAACGTTGGGAACTAGGTGTGGGCTGCATTCCACGTGGTCCGTGCCGTAGCTAACGCATTAAGTTCCCCGCCTGGGGAGTA CGGCCGCAAGGCTAAAACTCAAAGGAATTGACGGGGGCCCGCACAAGCAGCGGAGCATGTGGCTTAATTCGACGCAACGCGAAG AACCTTACCAAGGCTCGACATGCATCGGAAGCGGTCGGAGACGGTCGTGCCCTTGTGGTCGGTGTACAGGTGGTGCATGGCTGT CGTCAGCTCGTGTCGTGAGATGTTGGGTTAAGTCCCGCAACGAGCGCAACCCTTGTCTCGTGTTGCCAGCAGGCCTTTGTGGTG CTGGGGACTCACGGGAGACCGCCGGGGTCAACTCGGAGGAAGGTGGGGACGACGTCAAGTCATCATGCCCCTTATGTCTTGGGC TGCACACGTGCTACAATGGCTGGTACAATGAGTTGCGATGCCGTGAGGTGGAGCGAATCTCAAAAAGCCGGTCTCAGTTCGGAT TGGGGTCTGCAACTCGACCCCATGAAGTCGGAGTTGCTAGTAATCGCAGATCAGCAGTGCTGCGGTGAATACGTTCCCGGGCCT TGTACACACCGCCCGTCACGTCACGAAAGTCGGTAACACCCGAAGCCGGTGGCCTAACCTCTTTGTGGGGAGGGAGTCGTCGAA TGGTGGGATCTGGCGATTGGGACG ACGTGGCAATCTGCCCTGCACTCTGGGATAAGCCTTGGAAACGGGGTCTAATACCGGATATGACATGGGAGCGCATGTTTCTGT GTGGAAAGTTTCGGCGGTGTAGGATGAGCTCGCGGCCTATCAGCTTGTTGGTGGGGTGATGGCCTACCAAGGCGACGACGGGTA GCCGGCCTGAGAGGGCGATCGGCCACACTGGGACTGAGACACGGCCCAGACTCCTACGGGAGGCAGCAGTGGGGAATATTGCAC AATGGGCGAAAGCCTGATGCAGCGACGCCGCGTGGGGGATGACGGCCTTCGGGTTGTAAACCTCTTTCAGCAGGGAAGAAGCCT TTGGGTGACGGTACTTGCAGAAGAAGCACCGGCTAACTACGTGCCAGCAGCCGCGGTAATACGTAGGGTGCGAGCGTTGTCCGG AATTATTGGGCGTAAAGAGCTCGTAGGCGGCTTGTTGCGTCGGATGTGAAAGCCCGGGGCTTAACCTCGGGTCTGCATTCGATA CGGGCAGGCTGGAGTTCGGTAGGGGAGATCGGAATTCCTGGTGTAGCGGTGAAATGCGCAGATATCAGGAGGAACACCGGTGGC GAAGGCGGATCTNTGNGCCGATACTGACGCTGAGGAGCGAAAGCGTGGGGAGCGAACAGGATTAGATACCCTGGTAGTCCACGC CGTAAACGTTGGGAACTAGGTGTGGGCTGCATTCCACGTGGTCCGTGCCGTAGCTAACGCATTAAGTTCCCCGCCTGGGGAGTA CGGCCGCAAGGCTAAAACTCAAAGGAATTGACGGGGGCCCGCACAAGCAGCGGAGCATGTGGCTTAATTCGACGCAACGCGAAG AACCTTACCAAGGCTCGACATGCATCGGAAGCGGTCGGAGACGGTCGTGCCCTTGTGGTCGGTGTACAGGTGGTGCATGGCTGT CGTCAGCTCGTGTCGTGAGATGTTGGGTTAAGTCCCGCAACGAGCGCAACCCTTGTCTCGTGTTGCCAGCAGGCCTTTGTGGTG CTGGGGACTCACGGGAGACCGCCGGGGTCAACTCGGAGGAAGGTGGGGACGACGTCAAGTCATCATGCCCCTTATGTCTTGGGC TGCACACGTGCTACAATGGCTGGTACAATGAGTTGCGATGCCGTGAGGTGGAGCGAATCTCAAAAAGCCGGTCTCAGTTCGGAT TGGGGTCTGCAACTCGACCCCATGAAGTCGGAGTTGCTAGTAATCGCAGATCAGCAGTGCTGCGGTGAATACGTTCCCGGGCCT TGTACACACCGCCCGTCACGTCACGAAAGTCGGTAACACCCGAAGCCGGTGGCCTAACCTCTTTGTGGGGAGGGAGTCGTCGAA TGGTGGGATCTGGCGATTGGGACG |
| Strain Morphology Photos | |
| Morphological Description |